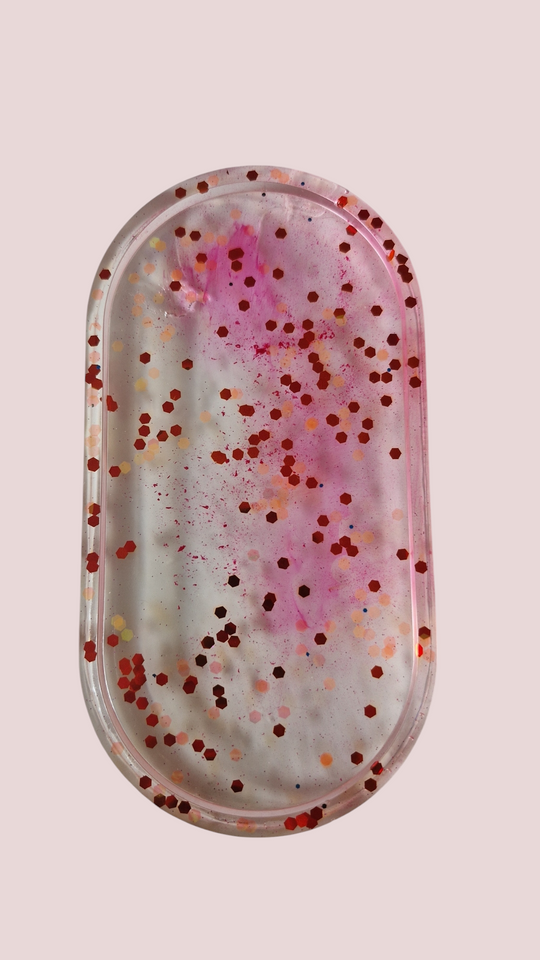
Vide poche

Error: Unable to add item to cart. Please try again later.
Prix régulier
€15,00
SEULEMENT LA GAUCHE
Indiquez moi la couleur et si vous souhaitez aussi des décorations ( paillette, feuille ......) dans les instructions
les gens regardent actuellement ce produit
Paiement sécurisé garanti